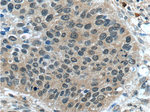
CWC25 Antibody in Immunohistochemistry (Paraffin) (IHC (P))
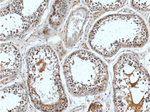
CWC25 Antibody in Immunohistochemistry (Paraffin) (IHC (P))

Search
Proteintech
CWC25 Polyclonal Antibody
{{$productOrderCtrl.translations['antibody.pdp.commerceCard.promotion.promotions']}}
{{$productOrderCtrl.translations['antibody.pdp.commerceCard.promotion.viewpromo']}}
{{$productOrderCtrl.translations['antibody.pdp.commerceCard.promotion.promocode']}}: {{promo.promoCode}} {{promo.promoTitle}} {{promo.promoDescription}}. {{$productOrderCtrl.translations['antibody.pdp.commerceCard.promotion.learnmore']}}

Please note: We are reviewing Western blot images included in the antibody testing data in our catalog, including those provided by third parties. Unless expressly labeled or annotated as “raw-unedited”, Western blot images included in the antibody testing data in our catalog may have been edited, optimized or otherwise adjusted for presentation.
产品信息
24416-1-AP
种属反应
宿主/亚型
分类
类型
抗原
偶联物
形式
浓度
规格
纯化类型
保存液
内含物
保存条件
运输条件
产品详细信息
Immunogen sequence: GPGGMVNRD EYLLGRPIDK YVFEKMEEKE AGCSSETGLL PGSIFAPSGA NSLLDMASKI REDPLFIIRK KEEEKKREVL NNPVKMKKIK ELLQMSLEKK EKKKKKEKKK KHKKHKHRSS SSDRSSSEDE HSAGRSQKKM ANSSPVLSKV PGYGLQVRNS DRNQGLQGPL TAEQKRGHGM KNHSRSRSSS HSPPRHASKK STREAGSRDR RSRSLGRRSR SPRPSKLHNS KVNRRETGQT RSPSPKKEVY QRRHAPGYTR KLSAEELERK RQEMMENAKW REEERLNILK RHAKDEEREQ RLEKLDSRDG KFIHRMKLES ASTSSLEDRV KRNIYSLQRT SVALEKNFMK R (76-425 aa encoded by BC008833)
靶标信息
The function of this protein remains unknown.
仅用于科研。不用于诊断过程。未经明确授权不得转售。
篇参考文献 (0)
生物信息学
蛋白别名: coiled-coil domain containing 49; Coiled-coil domain-containing protein 49; Pre-mRNA-splicing factor CWC25 homolog; Spliceosome-associated protein homolog CWC25
基因别名: 1300013D05Rik; AA473636; CCDC49; CWC25; R75228
UniProt ID: (Mouse) Q9DBF7
Entrez Gene ID: (Mouse) 67480




